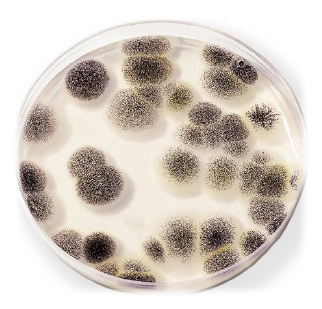
RTENOTITLE

사망시 삼가 고(故) 너 및 애완동물/가축의 명복을 왼손으로 비비고~ 오른손으로 비비고~ 아무튼 야무지게 빕니다.
| 이 문서는 아이돌 마스터에 관련된 내용을 다룹니다. 이 문서를 보다가 @ㅏ재가 되어서 담당 아이돌과 돔에 가지 않도록 주의하십시오. 프로듀사상! 도무데스요! 도무! |
| 이 문서는 귀찮아서 덜 썼거나 귀차니즘과 관련된 것에 대해 다루... 으으... 기차나.. |
| 주의. 이 문서는 이상성애나 그 대상, 또는 이상성애자와 관련된 문서입니다. 이 문서는 아동, 가족, 시체, 여장남자, 말, 배, 칼(자아), 주머니괴물, 홍차, 토끼, 오징어, 해골, 염소, 고추걸, 드래곤, 닭, 달, 총, 맛과자들, 국밥, 로봇, 할머니, 야채, 외계인 등에게 마이크로소프트한 고기리벳을 박고 싶어하는 이상성욕의 소유자들 혹은 그 새끼들이 노리고 있는 표적들, 아니면 그러한 이상성애 그 자체에 대해 다루고 있습니다. 이딴 것들에 서지 않는 정상인들은 이 문서를 읽고 발기부전에 빠질 수 있으니 주의가 필요합니다. |
| 주의! 이 문서에서 서술하는 인물은 존나 똑똑합니다. 이 문서는 노오오력충도 따라갈 수 없는 천재적인 두뇌를 가진 인물에 대하여 서술하고 있으니 호구가 되기 싫으면 뒤로가기를 누르세요. |
| 이 문서는 금수저에 대해 다룹니다. 이 분은 1년에 은행이자로만 버는 돈이 1인당 PPP (PPP per capita)가 넘을 정도의 금수저를 가진 사람을 다룹니다. 그냥 이 분을 주인님으로 삼고 노예가 되어 열심히 후장이나 빠시기 바랍니다. |
| 이 문서는 파오후가 좋아하는 주제, 또는 파오후 그 자체를 다루고 있습니다. 이 문서는 평범한 사람들과 관련있는 주제를 소개하지 않습니다. 주변의 파오후에게나 이 문서를 추천해 주세요. |
| 우리 모두의 죽창을 필요로 하는 대상이나 행동, 사상에 대한 문서입니다. 이 문서는 우리들이 반드시 죽창을 들어 찔러야 하는 특정 대상, 해결책은 오로지 죽창뿐인 인물을 가리키고 있습니다. 죽창 앞에선 너도 한 방 나도 한 방 죽창... 주욱창을 가져와라... |
| 이 문서에서는 재평가를 받아야 하는 영웅이나 그런 대상을 다룹니다. 이 사람은 재평가되어야 하는 영웅입니다. 모두 우리들의 일그러진 영웅을 위해 잠시 묵념합시다. 대표적으로 한국의 16강 진출을 두팔걷고 도와주신 한반두가 있습니다. |
| 후타바 안즈(双葉杏) | |||
(평상시) (인간체) | |||
| 나이 | 17세 | ||
| 생일 | 9월 3일 | 별자리 | 꽃다운 처녀자리 |
| 키 | 139cm | 몸무게 | 30kg |
| 혈액형 | B형 | 쓰는 손 | 오른손 |
| 소속 | 346 프로덕션 | 유닛 | 캔디 아일랜드 해피해피트윈 LittlePOPS |
| B-W-H | 불명 | ||
| 취미 | 그딴거 없다. | ||
| 출신지 | 훗카이도 | ||
| 성우 | 이가라시 히로미 | ||
| 이미지 컬러 | #FFC0C0 | ||
| “ |
일하면 지는거라고 생각합니다. |
” |
— 후타바 안즈
|
후타바 안즈는 아이돌 마스터 신데렐라 걸즈의 니트아이돌이다.
움직이는것이 꼬막보다 둔한 놈이다.
일할 생각은 안하고 허구헌날 놀생각만 쳐하는 조교가 필요한 씨발년이다.
사실 스탯은 만땅인데 노오오오오력이 하기 싫을뿐이지 몰리면 스탯 만땅 발휘해서 순식간에 척척 해낸다. 퀴즈대회에선 계산기가 필요할 문제를 암산으로 풀어버린다. 재능충인듯. 그리고 또 퍼굴러다닌다. 이거 딱 말년이네.
어째서 나이는 학생인데 학교다니는 흔적이 어디에도 안보이는지, 훗카이도 출신에 이름도 순 일본인인데 천연 금발인건지, 키 140에 몸무게 30kg이라는 영양실조 뺨치는 상태인건지 모든것은 미궁속에 있다. 자라는것도 귀찮았다는 말 외엔 설명이 불가능하다.
명대사는 "안즈는 1주에 8일의 휴일을 원해!" 이다. ㄴ근데 이 대사 비틀즈 노래 제목에서 따온 거냐?
머가리에 생각이란것이 들어있지 않다는걸 잘 보여주는 대목이다.
ㄴ 그러나 9화를 보고 닥쳤다고 한다.. 634M 높이의 스카이트리에서 사과를 떨어트릴때 지면에 닿을때의 속력은?(중력가속도는 9.8M/s입니다~)
ㄴ병신 문과충새끼야 중력가속도는 9.8m/s^2 란다.
하는짓은 딱 말년 병장인데 행보관이 귀신같이 잡아간다.
하도 귀차니스트라 디시위키 귀차니즘 틀에 떡하니 얼굴이 박혀있다.
이년은 너무 귀차니스트인 나머지 동인지중에서 강간당해도 귀찮다고 반항하지않고 그냥 당하는 또라이년이다.
BD특전 소책자에서 사무소에 올때 택시를 이용한다는 것이 밝혀지고, 용돈은 받아서 쓴다기 보다는 그냥 마음껏 쓰고 있다고 하여 적어도 애니메이션 기준으로는 기만자임이 확실해졌다. 덤으로 일본택시는 킴치택시가 100원 오를걸 한번에 90엔씩 오른다. 숫자에 약하고 계산하는것도 귀찮은 디시 앰생들을 위해 원으로 적어주면 한번에 900원씩 오른다는 뜻이다.
부모가 도쿄에 집도 사주고 홋카이도에 땅도 있고..씹기만자 금수저 확정
금수저에 재능충을 둘다 취하고 있기 때문에 신데마스에서 누구보다 죽창이 시급한 년이다.
데레스테 할로윈 이벤트의 룸에서 다른 아이돌들이 관짝을 열면 유령이나 박쥐가 나오는데 이년이 열면 버섯이 쏟아진다. 레알 곰팡이년 인증. 참고로 이년 못지않는 또라이년인 프레데리카도 버섯 나옴.
얘 처음 설정으로 패션에 넣어야 했다. 오랜 커플인 키도 솟고 합삐↑도 솟고 말할 때 뒷말 음정도 솟는 파괴거인과도 맞춰지는 점과, 데레스테에서 패션 타입 애들 곡이 대체로 정신 나간 패턴인 상황이니 그 미친 안즈의 노래도 패션에 전혀 어색하지 않다는 점이 있다.
결정적으로 하는 게 없어서 영역을 넓히지도 못하는 곰팡이가 큐-트할리 없다. 참고로, 큐트에는 노력충이 있다.
ㄴ 패션이 없는데 어떻게 패션에 넣냐?
평행세계의 인물로 메우 메우가 있는데, 얘는 안즈와 반대로 맨날 일만 하는 노예다. 소오름.
정수리에 코박고 솔솔 올라오는 묵은똥내 스읍 들이마셔서 뒈져버리고싶다.
그녀의 친구들
히라사와 유이
도마 우마루
모리쿠보 노노
토가시 요시히로
양영순
기안84
후타나리
푸른곰팡이
디시인
유니(프리코네) - 얘 별명도 곰팡이다.